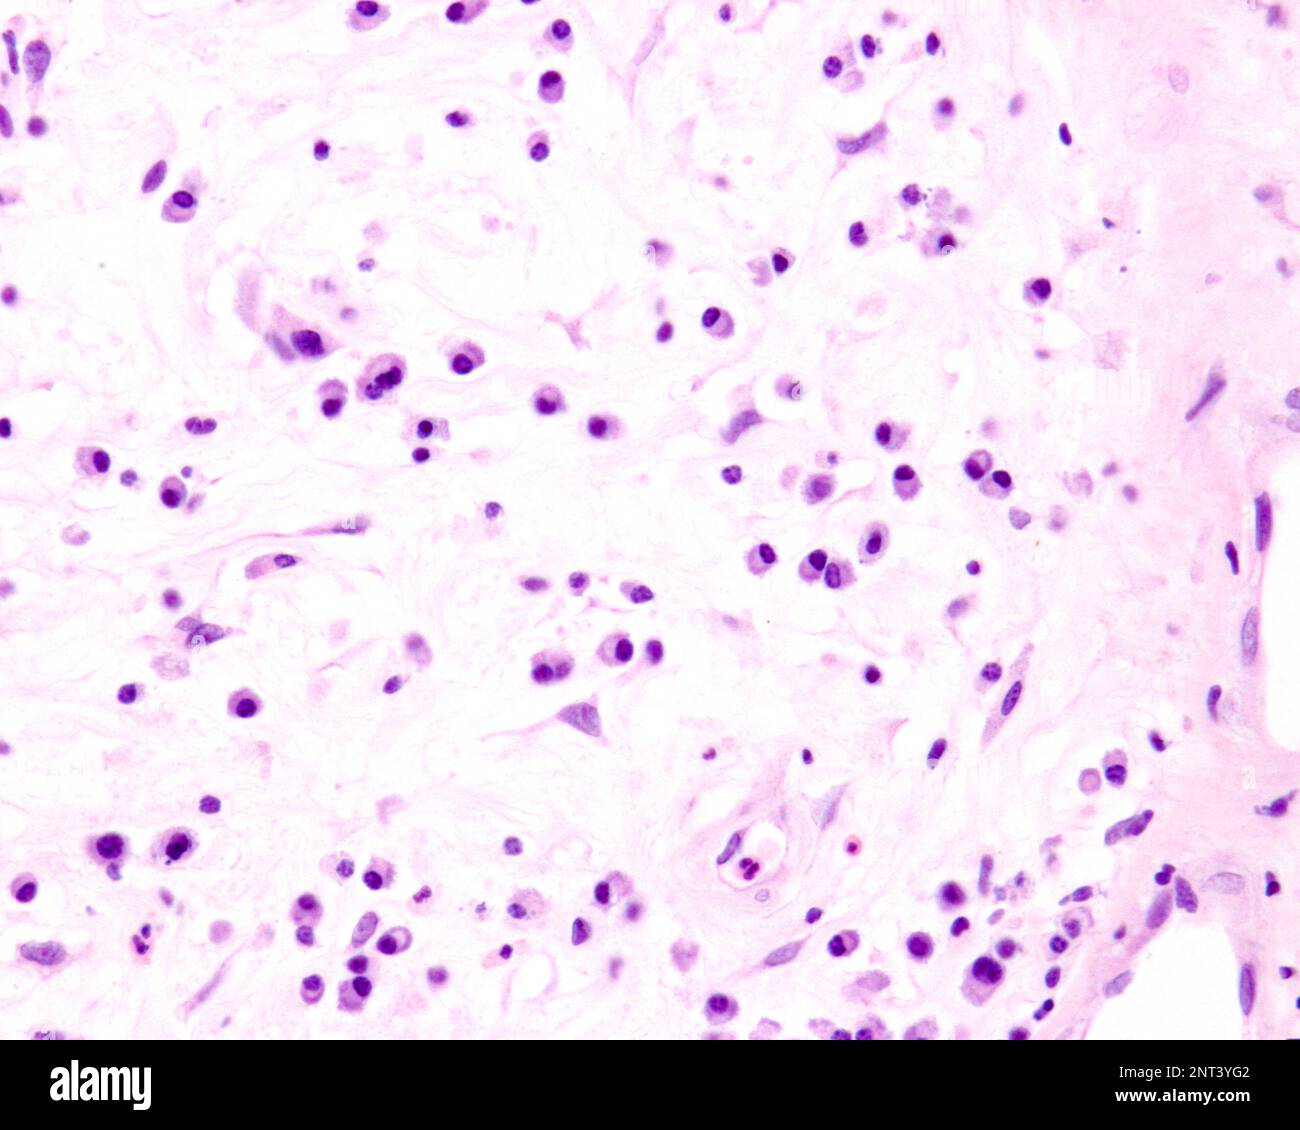
Plasmazellen sind B-Lymphozyten, die durch die Anwesenheit von Antigenen aktiviert werden, die große Mengen von Antikörpern absondieren. Sie treten in Geweben auf, die von c betroffen sind Stockfoto

Plasmazellen sind B-Lymphozyten, die durch die Anwesenheit von Antigenen aktiviert werden, die große Mengen von Antikörpern absondieren. Sie treten in Geweben auf, die von c betroffen sind
RFID:Bild-ID:2NT3YG2
Bilddetails
Bildanbieter:
Jose CalvoBild-ID:
2NT3YG2Dateigröße:
33,8 MB (855,2 KB Komprimierter Download)Freigaben (Releases):
Model - nein | Eigentum - neinBenötige ich eine Freigabe?Format:
3840 x 3072 px | 32,5 x 26 cm | 12,8 x 10,2 inches | 300dpiAufnahmedatum:
8. Februar 2023Weitere Informationen: